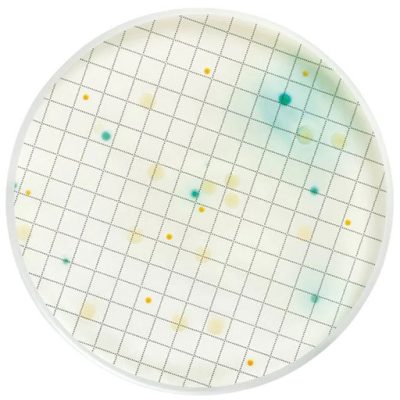
محیط کشت هکتون انتریک آگار  ایبرسکو  گرید آزمایشگاهی

محیط کشت هارت اینفیوژن براث ایبرسکو گرید آزمایشگاهی
نام انگلیسی: Heart Infusion Broth
شناسه محصول:
bu1089
دسته: کالای زیستی, محیط کشت, محیط کشت هارت اینفیوژن براث Heart Infusion Broth
برچسب: Heart Infusion Broth, محیط کشت هارت اینفیوژن براث
315,000 تومان – 950,000 تومانمحدوده قیمت: 315,000 تومان تا 950,000 تومان
20
نفر در حال مشاهده این محصول هستند!